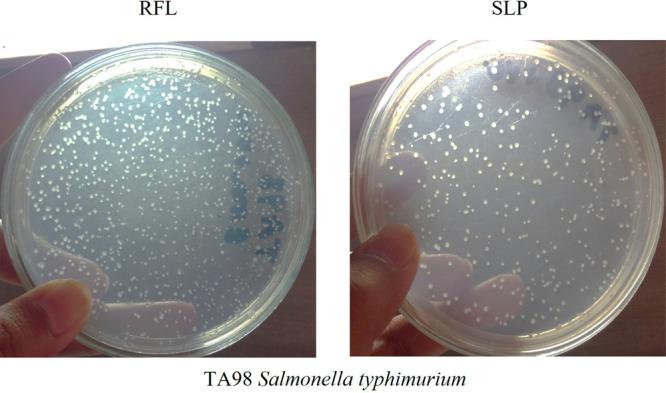
https://cdn.ncbi.nlm.nih.gov/pmc/blobs/0449/9948205/bd859efecb16/ao2c08102_0005.jpg

针对病毒疾病的乳管蛋白细胞遗传毒性潜力的功能研究。
Functional Studies of Cytogenotoxic Potential of Laticifer Proteins of against Viral Disease.
作者信息
Saher Uzma, Omer Muhammad Ovais, Javeed Aqeel, Anjum Aftab Ahmad, Rehman Kanwal, Awan Tanzeela, Saleem Gulbeena, Mobeen Ameena
机构信息
Department of Pharmacology and Toxicology, University of Veterinary and Animal Sciences, Lahore 54000, Pakistan.
Department of Pharmacy, The Women University, Multan 60000, Pakistan.
出版信息
ACS Omega. 2023 Feb 13;8(7):7119-7127. doi: 10.1021/acsomega.2c08102. eCollection 2023 Feb 21.
Plant products are widely used for health and disease management. However, besides their therapeutic effects, some plants also have potential toxic activity. is a well-known laticifer plant having pharmacologically active proteins playing a therapeutically significant role in curing diseases like inflammatory disorders, respiratory diseases, infectious diseases, and cancers. The present study was aimed to investigate the antiviral activity and toxicity profile of the soluble laticifer proteins (SLPs) obtained from . Different doses of rubber free latex (RFL) and soluble laticifer protein (ranging from 0.019 to 10 mg/mL) were tested. RFL and SLPs were found to be active in a dose-dependent manner against NDV () in chicken embryos. Embryotoxicity, cytotoxicity, genotoxicity, and mutagenicity of RFL and SLP were examined on chicken embryos, BHK-21 cell lines, human lymphocytes, and , respectively. It was revealed that RFL and SLP possess embryotoxic, cytotoxic, genotoxic, and mutagenic activity at higher doses (i.e., 1.25-10 mg/mL), while low doses were found to be safe. It was also observed that SLP showed a rather safer profile as compared to RFL. This might be due to the filtration of some small molecular weight compounds at the time of purification of SLPs through a dialyzing membrane. We suggest that SLPs could be used therapeutically against viral disorders but the dose should be critically monitored.
植物产品广泛用于健康和疾病管理。然而,除了其治疗作用外,一些植物还具有潜在的毒性活性。[植物名称]是一种著名的乳汁管植物,其具有药理活性蛋白,在治疗炎症性疾病、呼吸系统疾病、传染病和癌症等疾病方面发挥着重要的治疗作用。本研究旨在调查从[植物名称]中获得的可溶性乳汁管蛋白(SLPs)的抗病毒活性和毒性特征。测试了不同剂量的无橡胶乳胶(RFL)和可溶性乳汁管蛋白(范围为0.019至10mg/mL)。发现RFL和SLPs对鸡胚中的新城疫病毒(NDV)具有剂量依赖性活性。分别在鸡胚、BHK-21细胞系、人淋巴细胞和[细胞名称]上检测了RFL和SLP的胚胎毒性、细胞毒性、遗传毒性和致突变性。结果表明,RFL和SLP在高剂量(即1.25 - 10mg/mL)时具有胚胎毒性、细胞毒性、遗传毒性和致突变性,而低剂量被认为是安全的。还观察到,与RFL相比,SLP显示出相对更安全的特征。这可能是由于在通过透析膜纯化SLPs时过滤了一些小分子化合物。我们建议SLPs可用于治疗病毒疾病,但剂量应严格监测。